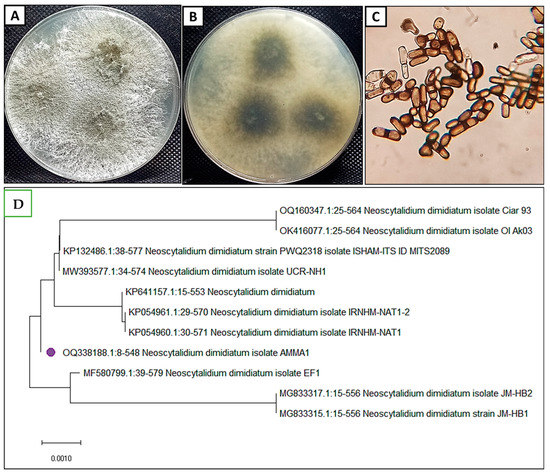

Abstract
Fungal plant diseases are considered one of the most destructive diseases for plants. In this current study, Neoscytalidium dimidiatum as a fungal plant pathogen was isolated from an infected Carum carvi L. plant (C. carvi) for the first time and controlled it using clove essential oil nanoemulsion (CEONE). This fungal plant pathogen was identified morphologically and genetically, then deposited in the gene bank under accession number OQ338188. CEONE was prepared and characterized using DLS, Zeta potential, and TEM analysis. The characterization results illustrated that the size of CEONE was lower than 100 nm, which was confirmed by TEM, which appeared spherical in shape. Results revealed that CEONE has promising antifungal activity towards N. dimidiatum, where inhibition percentages of CEONE at concentrations of 5000, 3000, and 1000 ppm were 82.2%, 53.3%, and 25.5%, respectively. At the pot level, N. dimidiatum was highly virulent on C. carvi, and CEONE and CEO were highly effective against N. dimidiatum blight disease, with 71.42% and 57.14% protection, respectively. Moreover, results revealed that there was a vast improvement in root length, plant height, and leaves. Additionally, the application of CEONE and CEO induced plant resistance by modifying proline, phenol, hydrogen peroxide, malondialdehyde, and antioxidant enzymes. In conclusion, N. dimidiatum was highly virulent on C. carvi but can be effectively reduced by CEONE through the eco-friendly method.
1. Introduction
C. carvi is a medicinal, commercial, and economically vital plant with many benefits and medicinal importance [1]. Among the many benefits of C. carvi, this herb was used by the ancient Egyptians, Greeks, Romans, and Arabs. Ripe seeds contain volatile C. carvi oil, which contains carvone, limonene, and proteins that aid digestion, repel gases, and are analgesics for colic [2,3]. C. carvi suffers from a group of diseases that affect plant growth and production and reduce its market value [4]. The soil, whether organic or conventional, is a source of pathogenic fungi that cause human and plant diseases, including Fusarium, Alternaria, Curvularia, and Neoscytalidium dimidiatum [5,6]. N. dimidiatum is common and has a wide range of plant hosts, such as Peltophorum pterocarpum and Thespesia populnea [7]. Symptoms of this fungus include citrus branch wilt, decline, and death [8]. N. dimidiatum can be controlled by the chemical fungicides Protifert, Cidely Top, and Amistrar Top, both in vitro and in vivo [9]. The eradication of plant diseases in order to maintain the economic importance of cultivated plants is very important, but it is necessary to find alternatives to chemical pesticides that are no less dangerous than the disease itself [10,11,12]. The application of plant extracts (PE) is a unique way to combat plant diseases [13,14]. Plants have interior resistance tools that can be encouraged using biological or natural inducers [15,16,17]. The usage of nanomaterials, especially biologically prepared nanomaterials, in the field of agriculture, with the aim of increasing plant yield and increasing plant resistance against biotic and abiotic plant stresses, is unique of the greatest advanced important methods [18,19]. Recently, systemic resistance has gained wide attention, and thought has begun to turn towards finding natural stimulants that have the capability to combat pathogenic microbes with simultaneous induction of systemic resistance in the plant [20,21,22]. Aromatic PE containing oils full of antioxidants, phenolics, and antimicrobials showed success against phytopathogenic fungi and marked improvement in plant health [23,24,25]. Vegetable oil emulsion has been used in recent periods to increase plant production and raise the efficiency of plant growth obstacles because it contains plant-stimulating substances in nano-form, which gives it very high efficiency and does not negatively affect the environment or human strength [26,27]. The highest goal of this work is to evaluate the virulence of N. dimidiatum on the Carum carvi L. plant and to evaluate CEONE as an alternative biofungicide against N. dimidiatum on Carum carvi L.
2. Materials and Methods
2.1. Isolation of the Pathogen
Infected C. carvi plants were collected from Abshaway (Fayoum governorate, Egypt). The isolation of pathogens takes place according to Purdy [28]. Infected stems were washed repeatedly with tap water several times, cut into 1 cm2 and superficially sterilized with 1% NaClO for 120 s, splashed with sterilized water, and dried with sterilized filter papers, then plated onto potato dextrose agar (PDA) medium, and incubated at 27 ± 1 °C for 7 days. Lastly, growing fungi were purified using hyphal tip techniques.
2.2. Identification of the Phytopathogenic Fungus
Macroscopic morphological features, including color, texture, pigmentation, growth rate, and diameter of colonies, and microscopic characteristics, including vegetative and reproductive components of the pathogen, were noted. The fungal isolate was identified based on the description of their pycnidial and mycelial anamorphs [29,30,31]. DNA extraction was carried out using a mini-preparation technique. Using a sterile loop, a loopful of fungal mycelia was aseptically put into a 1.5 mL Eppendorf tube that already contained 500 µL of lysis buffer (400 mM Tris-HCl [pH 8.0], 60 mM EDTA [pH 8.0], 150 mM NaCl, and 1% sodium dodecyl sulphate). The tube was then kept at room temperature for 10 min. After adding 150 µL of potassium acetate, pH 4.8 (5 M potassium acetate 60 mL, glacial acetic acid 11.5 mL, and distilled water 28.5 mL), the tube was quickly vortexed and then centrifuged at 10,000× g for 1 min to remove the cellular debris and precipitated proteins. The supernatant was poured into a second 1.5 mL Eppendorf tube and centrifuged once more than before. An equivalent volume of isopropyl alcohol was added when the supernatant was transferred to a fresh 1.5 mL Eppendorf tube. After a quick inversion mix, the tube was centrifuged at 10,000× g for 2 min, and the supernatant was discarded. The final DNA pellet was cleaned in 300 µL of 70% ethanol. The supernatant was discarded after being centrifuged for one minute at 10,000× g [32]. EZ-10 Spin Columns (BioBasic Inc., Markham, ON, Canada) was filled with the DNA pellet and centrifuged at 10,000× g for 10 min. The eluted DNA was kept at −20 °C after being eluted in 50 µL of 1x TE buffer. The Gene JET PCR Purification Kit (Thermo K0701, Boston, MA, USA) was used to purify the PCR product according to the manufacturer’s instructions. The internal spacer region was amplified with primers ITS1 (5′-TCC GTA GGT GAA CCT GCG G-3′) and ITS4 (5′-TCC TCC GCT TAT TGA TAT GC-3′), internal spacer regions were amplified using the PCR (http://willowfort.co.uk/, accessed on 6 March 2023). A volume of 25 µL of the master mix PCR, 0.16 mM of each deoxyribonucleoside triphosphate, 5 µL of Taq DNA polymerase buffer, 2.5 U of intron master mix (i-Taq TM) Taq DNA-dependent DNA polymerase, 0.2 mM of each primer, and 1 g of genomic DNA as template were included in the reaction volume of 50 µL. A 3 min initial denaturation at 95 °C was followed by 35 cycles of primer annealing at 50 °C for 1 min, denaturation at 95 °C for 1 min, and elongation at 72 °C for 2 min. The last extension stage was carried out for 10 min at 72 °C. Instead of template DNA, sterile deionized water was used as the negative control. A 1X TBE buffer (Tris base/boric acid/EDTA) was used to make red-safe-dyed agarose gel (1.5%) for the experiment. The bands produced by agarose gel electrophoresis were seen under UV light after being conducted at 100 V. Prior to usage, PCR products were kept at 20 °C. The resulting PCR products were sequenced by sequencing ready reaction kit (Applied Biosystems, Foster, CA, USA) in macrogene company (10F, 254, Beotkkot-ro, Geumcheon-gu, Seoul Gasan-dong, World Meridian I). Evolutionary study was directed at molecular evolutionary genetics analysis MEGA-5 software [33].
2.3. Preparation of CEONE
CEO was0 extracted according to method used by Al-Shahrani, Mahfoud [34]. A volume of 10 mL of CEO and 5 mL of non-ionic surfactant Tween 80 were added slowly with gentle stirring until a homogeneous mixture formed. Then, water (85 mL) was added to reach the final mixture of each CEO to 100 mL, then stirred using a magnetic stirrer for 30 min. The mixture was sonicated for 30 min at 350 W, and all treated CEOs were placed in an ice bath during the time of work. CEO was prepared, as mentioned above, before without sonication.
2.4. Characterization of CEONE
The measurement of droplet size of CEONE was performed by a dynamic light scattering analysis using Zeta Nano ZS (Malvern Instruments, Worcestershire, UK) at 27 °C. Prior to measurement, 30 μL of CEONE was diluted with 3 mL of water at 25 °C. The CEONE particle size data were expressed as the mean of the Z-average of three independent batches. The droplet size and the poly disparity index (PDI) of the formulated CEONE were measured [35]. The Zeta potential measurement was performed by (NanoZS4700 nano series, Malvern Instruments, Worcestershire, UK) in distilled water, which was adjusted to a conductivity of 50 µS/cm with a 0.90% (w/v) sodium chloride solution. To carry out TEM, 20 microliters of diluted sample were placed on a film-coated 200-mesh copper specimen grid for 10 min, and the excess fluid was eliminated using filter paper. The grid was then stained with 1 drop of 3% phosphotungstic acid and allowed to dry for 3 min. The coated grid was dried and examined under the TEM microscope (Tecnai G20, Super twin, double tilt, FEI, Hillsboro, OR, USA), operating at 200 kV [36].
2.5. Antifungal Activity of CEONE
The activity of CEONE against N. dimidiatum was determined using the radial growth method [16]. CEONE was added to sterilize PDA flasks before solidifying to obtain the proposed concentrations of 1000, 3000, and 5000 ppm (v/v). Negative control was performed without addition of CEONE, but positive control was carried out by adding difenoconazole fungicide. The bactericide (Chloramphenicol, 0.1 mg/L) was added to the medium to avoid bacterial contamination. All plates for each treatment were inoculated, then incubated at 25 ± 1°. Linear growth of the fungus was measured when mycelial growth of fungus filled a plate of its control. Reduction in fungal growth was calculated according to the following equations:
where A means the linear growth in control without CEONE and B means the linear growth of treated fungus.
2.6. Pathogenicity Test
The pathogenesis experiment was conducted to prove the ability of the fungus to cause infection. The pathogenicity test was performed on 10 replications of healthy C. carvi seeds germinated in the Faculty of Science at Al-Azhar University. N. dimidiatum fungus was cultured on autoclaved sorghum grains medium (100 g corn + 50 g washed sand + 100 mL water) at 27 °C for 15 days. Soil infestation with above-isolated fungus was applied at the rate of 1% w/w (fungus/soil) in pots 30 cm in diameter. The infection took place in the soil in which it was grown, on three seeds per pot. Plants were evaluated for symptoms and disease progression. Once disease symptoms appeared, fungi were isolated from infected stems on a PDA and compared to inoculated fungus.
2.7. Pot Experiment
Seeds of C. carvi germinated and were sown to obtain seedlings; 3 seedlings (45 days old) per pot (30 cm in diameter) containing a mixture of sand and clay (1:3 w/w) with a total weight of 4 kg were sown. The pots were distributed with 10 replicates for each treatment. The management was organized as follows: T1—healthy control, T2—infected control, T3—infected plants treated with CEO at the rate of 5 mL/L water, T4—infected plants treated with CEONE at the rate of 5 mL/L water, and T5—infected plants treated with Difenoconazole fungicide at the rate of 3 mL/L water. Pathogenicity was performed as previously described, and plants were sprayed with treatments after 1 week of cultivation (20 mL per plant once every week for 3 weeks) to assess plant resistance, record disease symptoms, and take samples for biochemical tests from plant samples 45 days after infection.
2.8. Morphological Indicators of Resistance
2.8.1. Disease Index
The disease index is considered the first and most basic criterion for the extent of disease development as well as for the direct determination of the extent of the efficiency of treatments to control plant disease. DI and protection were evaluated by the following equation: percent disease index (PDI) = (1n1 + 2n2 + 3n3 + 4n4)100/4nt, where n1–n4 represents the number of plants in each class and nt is the total assayed plants. Protection% = A − B/A 100, where A is the percent disease index (PDI) in infected plants, and B is the PDI in treated infected plants [37]. Disease symptoms were recorded 45 days after infection, and disease severity and protection ratio were calculated, as described using 5 score classes: 0 (no symptoms), 1 (slight yellow of leaves), 2 (moderate yellow plant), 3 (chlorosis), and 4 (canker and completely destroyed).
2.8.2. Plant Growth
Three random plants from each treatment were used to determine the following growth parameters: plant height (cm), root length (cm), and number of leaves per plant.
2.8.3. Metabolic Indicators for C. carvi Resistance
The physiological characteristics are clearly affected when there is any plant disease and an imbalance and deviation from the normal rate occur. Free proline was estimated by the method of Bates et al. [38], but the method of Dai et al. [39] was applied to measure the plant phenolics. The procedure of [40] was used to assay the MDA content in fresh plant leaves. Fresh C. carvi leaves also were established for hydrogen peroxide H2O2 content [41]. Accepted method of Srivastava [42] was used to determine POD. The activity of PPO enzyme was splendid using the technique of Matta [43].
2.9. Statistical Analysis
A one-way analysis of variance (ANOVA) was applied to the resulting data. LSD by CoStat (CoHort, Monterey, CA, USA) was applied to demonstrate statistically relevant variances at p < 0.05 [44].
3. Results and Discussion
Caraway (Carum carvi L.) is widely cultivated all over the world. It is among the widely used spices as crude or essence in various food products for its pleasant flavor and antispoilage properties. However, the economic importance of C. carvi always suffers from different fungal diseases. In this current study, both healthy (Figure 1A) and infected C. carvi were collected, where the infected appeared weak and had black lesions on the stem and leaves (Figure 1B). Additionally, infected C. carvi was examined microscopically, where results illustrated that it was infected with Neoscytalidium sp. (Figure 1C).

Figure 1.
Healthy Carum carvi plant (A), Stem and foliar blight symptoms on Carum carvi plants (B), N. dimidiatum under light microscope (400×) (C).
3.1. Morphological and Molecular Identification of the Isolate Pathogen
This fungal isolate was isolated from a C. carvi plant and identified morphologically and genetically, as illustrated in Figure 2. Morphological identification of the fungal isolate on PDA medium illustrated that the fungus appeared white to olive green in color with grey to black pigmentation (Figure 2A,B). Furthermore, the fungus appeared to grow quickly, with a diameter of 40–50 mm. Conidia were appeared septated with brown coloration and rod-shaped as they matured (Figure 2C). To confirm the morphological identification, molecular identification was carried out. Results revealed that the fungal isolate was identified as N. dimidiatum with a similarity of 99% according to a BLAST search on NCBI. Additionally, this sequence was deposited in the Gene Bank with accession number OQ338188. To our knowledge, this is the first report to isolate N. dimidiatum from a Carum carvi plant. In a previous study, N. dimidiatum was isolated from red-fleshed dragon fruit (Hylocereus polyrhizus) in Malaysia, which causes stem canker [45]. Additionally, Derviş, Özer [46] isolated N. dimidiatum from infected potatoes in Turkey, which is causing tuber rot in potatoes.
Figure 2.
Identification of N. dimidiatum includes surface (A), reverse color and pigmentation on PDA (B), conidia under a light microscope (C), and a phylogenetic tree (D).
3.2. Characterization of CEONE
3.2.1. DLS and Zeta Potential
The effect of ultrasonication on the droplet size of CEONE was determined. (Figure 3A) shows the stable CEONE prepared by the ultrasonication method for 30 min at 350 W after 30 days of storage at room temperature. Tween 80 was used as a surfactant for its high HLB value, which favors the formulation of oil-in-water emulsions. Additionally, small molecule surfactants such as Tween 80 get rapidly adsorbed onto the emulsion droplet surface, so they are more effective in decreasing droplet diameter than polymeric surfactants [47]. The CEONE droplets were in nanoform (around 91.3 nm). The polydispersity index (PDI) for particles was good (0.448). The medium hydrodynamic diameter increased proportionally to the increase in the concentration of added clove oil, related to the increase in the internal volume of the nanoparticle occupied by the oil. This increase in internal volume indicates the increase in the supply of CO within the particle as its concentration increases. This could be also attributed to the possible changes in the organic viscosity and physicochemical properties of solvent release into water [48]. The zeta potential was also good (−46.3 mV). The decrease in particle size may depend on the ability and performance of surfactants. Stirring is known to reduce the size of droplets in an oil-in-water emulsion [49]. The fabrication of nano-emulsion with lesser droplet size in the presence of double bonds in the nonpolar chain of non-ionic surfactants was evaluated by [50,51].

Figure 3.
DLS of CEONE (A) and zeta potential of CEONE (peak at—46.3 mV) (B).
3.2.2. Transmission Electron Microscopy (TEM)
The morphology of the nanoemulsion was visualized by TEM analysis, as shown in Figure 4. TEM characterization of CEONE exhibited its actual size and shape; the droplets in the nanoemulsion appeared dark. The TEM micrograph showed that CEONE was spherical in shape and moderately mono- or di-dispersed. CEONE droplets were in the range of 36.4–57.1 nm, as shown in Figure 4. The droplet size was well correlated with the results obtained from droplet size analysis using the dynamic light scattering technique [44,45].

Figure 4.
Transmission electron microscopic image of CEONE.
3.3. Antifungal Activity of CEONE
The antifungal activity of CEONE toward N. dimidiatum using the radial growth method was evaluated, as shown in Figure 5. Results revealed that CEONE has promising antifungal activity towards N. dimidiatum, with decreasing linear fungal growth as CEONE concentration increased. The growth diameters of N. dimidiatum at 0 ppm, 1000 ppm, 3000 ppm, and 5000 ppm of CEONE were 100, 67, 42, and 16 mm, respectively. Moreover, CEONE at a concentration of 5000 ppm exhibited the highest inhibition among the other concentrations applied, where the inhibition percentage was 82.2%. On the other hand, inhibition percentages decreased at concentrations of 1000 and 3000 ppm, where they were 25.5% and 53.3%, respectively. The phenolic eugenol component in clove showed a high level of activity against plant pathogenic fungi [52,53]. Eugenol in clove oil acts on the cell membrane by a mechanism that seems to involve the inhibition of ergosterol biosynthesis [54]. Eugenol, known to be a lipophilic compound, can enter between the fatty acid chains that make up the membrane lipid bilayers, thus altering the fluidity and permeability of cell membranes [55,56]. CEONE inhibited not only radial growth but also sporulation and pigmentation of the pathogen. Several authors have demonstrated that eugenol in clove oil alone could reduce the growth rate of mold and also reduce mycotoxins produced by mold [57,58].

Figure 5.
Effect of different concentrations of CEONE on radial growth (A,B), and inhibition % (C) of N. dimidiatum. Letters a,b,c,d mean power of significance.
3.4. Disease Assessment
The disease incidence indicator of the plant is the first and most basic criterion for the evaluation of any plant disease, and the severity of the disease is measured depending on the severity of the symptoms. According to the data in Table 1, N. dimidiatum infection has a high disease index (DI) of 87.5%. Reducing the seriousness of the disease is the first sign of the efficacy of the tested CEO and its CEONE in stimulating plant resistance. According to the data, treatment with difenoconazole fungicide, CEONE, and CEO resulted in high protection (77.14%, 71.42%, and 57.14%, respectively), and the lowest PDI (20%, 25%, and 37.50%). This reduction in DI by application of CEO may be due to the CEO having highly antimicrobial activity through an antioxidant mechanism [59]. Many studies explained the high antifungal activity of CEO against plant pathogens [60,61].

Table 1.
Protection of CEO and CEONE and difenoconazole against N. dimidiatum.
3.5. Vegetative Growth
The morphology and external characteristics of the plant express the physiological state of the plant. When the physiological processes proceed in a healthy manner, this clearly shows the reason for the vegetative growth of the plant. On the other hand, when any deviation occurs in the growth of the plant, this indicates the presence of biotic or abiotic stresses. The results shown in Figure 6 indicate that the infection of C. carvi plants with N. dimidiatum caused a severe decrease in all morphological traits compared to the healthy control, where there is a decrease in root length, plant length, and number of leaves (53.01%, 35.29%, and 51.88%). N. dimidiatum has been found on a wide variety of plants in many countries around the world, causing wilting disease [37,62,63]. Fungal infection causes a detrimental effect on vegetative growth characteristics, which is negatively reflected in all physiological processes. Our data in the present research showed that N. dimidiatum fungus triggered a severe decrease in vegetative growth. The findings of a recent study approve of these destructive effects by infection [9,64]. This deterioration can be explained by a disturbance in the physiological processes, which results in a severe deterioration in the various growth characteristics. Inducing plant immunity using bio inductors is the ideal solution to eliminate pathogens and improve plant growth. As shown in the results in Figure 6, the use of the tested inducers (CEO, CEONE, and difenoconazole) led to the recovery of the infected plants, as they showed a significant improvement in the growth characteristics compared to the infected plants alone. Results indicated that CEONE was the best treatment, as the plants treated with CEONE recorded an increase in plant length, root length, and the number of leaves (92.3%, 48.01%, and 24.97%) compared to difenoconazole treatment (66.66%, 46%, and 20.03%) and CEO (46.1%, 23.09%, and 5.9%). This improvement can be explained by the fact that CEO and CEONE contain stimulating compounds for plant growth, in addition to their anti-fungal abilities, which induce the growth of plants under unfavorable conditions [65,66,67]. The effect of the active compounds in CEO may be directly on the fungus, as previously mentioned [57]. Therefore, it is not excluded that the effect of some compounds in the CEO and CEONE is due to the stimulation of the plant’s defensive means, which made it more resistant to the effect of fungus and corrected the physiological defect, which led to the improvement of growth characteristics [68].

Figure 6.
Effect of CEO and CEONE on vegetative growth of C. carvi metabolic indicators. Letters a,b,c,d,e mean power of significance.
3.6. Proline and Phenol Indicators
Proline and phenols are among the most important indicators of the occurrence of external stresses on the plant. They are among the indicators that change greatly when the plant is infected with diseases caused by a live or abiotic pathogen. The impact of the pathogenic fungus N. dimidiatum on the contents of proline in C. carvi plants and their management by CEO and CEONE and difenoconazole were clarified in Figure 7. Under biotic stress, plants accumulate proline for its direct role as an osmosis regulator to protect cells from free radical toxicity [69,70]. Infection with the pathogenic fungus N. dimidiatum significantly boosted proline contents in C. carvi plants by 42.93% in comparison with uninfected plants. Regarding the infected C. carvi plants, proline contents were significantly decreased in response to the application of CEONE, CEO, and difenoconazole by 25.54%, 16.57%, and 15.5%, respectively, compared with the infected control. Regarding the application of CEONE or CEO, previous studies have documented that CEO and CEONE induce systemic protection against phytopathogens [71,72,73]. Our findings are in accordance with the results of [74]; the author demonstrated that fungicide treatment increased proline levels in the infected plants. Phenolic compounds of C. carvi were affected due to the infection with N. dimidiatum and the application of CEO, CEONE, and difenoconazole. The pathogenic fungus N. dimidiatum significantly augmented the contents of phenols in C. carvi by about 14.56% relative to uninfected plants. When plants are subjected to biotic stress, phenols play a protective role [75]. An increase of phenols in the infected plants by pathogens was noted in numerous studies [76,77,78]. Additionally, in infected C. carvi, phenol contents were significantly increased relative to infected control plants in response to the application of CEONE, CEO, and difenoconazole by 83.05%, 81.35%, and 9.32%, respectively. CEO is very rich in phenolic acids, as well as being one of the most powerful natural antioxidants [79]. Antioxidants play an important role in capturing free radicals and protecting plant cells from damage, in addition to building cell walls [80,81]. Therefore, we can say that CEO and CEONE are vital stimulators of plant immunity and safe alternatives to chemical pesticides. These results recommend that each improvement or increase in proline and phenol stimulate resistance in the host to challenge the stress [82,83].

Figure 7.
Effect of CEO and CEONE on proline and phenol content of C. carvi. Letters a,b,c,d,e mean power of significance.
3.7. MDA and H2O2
The measurement of H2O2 and MDA are necessary indicators to determine the extent of plant disease progression because they indicate the plant’s ability to suppress free radicals that lead to the deterioration of plant growth. In Figure 8, the impact of the pathogenic fungus N. dimidiatum on the contents of H2O2 and MDA in C. carvi plants and their management by CEO, CEONE, and difenoconazole are clarified. Infection with the pathogenic fungus N. dimidiatum significantly boosted MDA and H2O2 in C. carvi plants by 71.8% and 93.1%, respectively, in comparison with uninfected plants. Biotic stresses caused oxidative stress, which led to serious disorders in the plant cell and a rise in the content of H2O2 and MDA [84,85]. Reduction of the contents of MDA and H2O2 is the key sign of the efficacy of the tested CEO and CEONE in stimulating plant resistance. Regarding the infected C. carvi, MDA and H2O2 were significantly decreased in response to the application with CEONE, CEO, and difenoconazole by (34.52%, 27.51%, and 27.37%) and (44.06%, 42.1%, and 40.88%), respectively, compared with the infected control. Our results in this current study indicated that the addition of CEONE and CEO to the challenged C. carvi presented a significant reduction in the content of H2O2 and MDA, and this can be explained by the capability of CEONE to stimulate resistance by accumulating the antioxidants responsible for protection [86,87].

Figure 8.
Effect of CEO and CEONE on MDA and H2O2 content of C. carvi. Letters a,b,c,d,e mean power of significance.
3.8. Antioxidant Enzymes Activity
Antioxidant enzymes (AOE) are among the most important indicators through which we can observe the virulence of the plant disease as well as the extent of the efficacy of the treatments on the severity of the plant disease. So, the activity of POD and PPO enzymes was measured, using it to note the severity of the C. carvi blight disease. The impact of the pathogenic fungus N. dimidiatum on the activities of (AOE) (POD and PPO) in C. carvi and their management by CEO, CEONE, and difenoconazole are clarified in Figure 9. Infection with the pathogenic fungus N. dimidiatum significantly boosted the activities of antioxidant enzymes (AOE) POD and PPO in C. carvi by 126% and 68.57%, respectively, in comparison with uninfected plants. Numerous (AOE) has been correlated with disease [88,89]. Interestingly, results in Figure 9 indicated that the addition of CEONE as well as COE to infected plants stimulated the activation of AOE more than the fungicide, compared with the infected control. The plant presented various approaches to managing disease as they boost the activity of AOE to hold ROS at a reduced level in the cell [90].

Figure 9.
Effect of CEO and CEONE on PPO and POD content of Carum carvi. Letters a,b,c,d,e mean power of significance.
4. Conclusions
In this current study, the fungus N. dimidiatum was isolated from C. carvi for the first time. This strain was identified morphologically and genetically. Furthermore, CEONE was prepared using an eco-friendly method and then characterized using DLS, Zeta potential, and TEM analyses. The characterization results revealed that the size of CEONE was lower than 100 nm, which was confirmed by TEM, where it appeared spherical in shape. Antifungal results illustrated that CEONE exhibited promising antifungal activity against N. dimidiatum. In an in vivo study, it was shown that C. carvi can be extremely affected by the N. dimidiatum fungus through high DI, a severe reduction in vegetative growth, and physiological markers, including proline, protein, H2O2, MDA, POD, and PPO enzymes by application of both CEO and CEONE. Through antagonistic activity and induced plant resistance, CEO and CEONE can reduce the harmful effects of N. dimidiatum.
Author Contributions
Conceptualization, A.H.H., A.M.A., M.M.H.H. and M.S.A.; Methodology, A.H.H., A.M.A., M.M.H.H. and M.S.A.; Software, A.H.H. and A.M.A.; Formal analysis, M.M.H.H., A.A.A.-A., H.A. and M.S.A.; Investigation, A.H.H., A.M.A., M.M.H.H., A.A.A.-A., H.A. and M.S.A.; Resources, A.H.H. and A.M.A.; Data Curation, A.H.H., A.M.A., M.M.H.H. and M.S.A.; Writing—original draft preparation, A.H.H., A.M.A., M.M.H.H. and M.S.A.; Writing—Review and Editing, A.H.H., A.M.A., M.M.H.H., A.A.A.-A., H.A. and M.S.A.; Supervision, A.H.H., A.M.A., M.M.H.H. and M.S.A. All authors have read and agreed to the published version of the manuscript.
Funding
The authors extend their appreciation to the researcher supporting project number (RSP2023R505), King Saud University, Riyadh, Saudi Arabia, for funding publication fees.
Data Availability Statement
All data and materials are available.
Acknowledgments
The authors would like to thank the Botany and Microbiology Department, Faculty of Science, Al-Azhar University, for promoting this research. Ornamental, Medicinal and Aromatic Plant Disease Department, Plant Pathology Research Institute, Agricultural Research Center (ARC), Giza, Egypt. Additionally, the authors extend their appreciation to the researcher supporting project number (RSP2023R505), King Saud University, Riyadh, Saudi Arabia, for funding this work.
Conflicts of Interest
The authors declare no conflict of interest.
References
- Gabler, J. Breeding for resistance to biotic and abiotic factors in medicinal and aromatic plants: General situation and current results in annual caraway (Carum carvi L. var. annum). J. Herbs Spices Med. Plants 2002, 9, 1–11. [Google Scholar] [CrossRef]
- Pickersgill, B. Spices. In The Cultural History of Plants; Routledge: Abingdon, UK, 2012; pp. 156–175. [Google Scholar]
- Nabhan, G.P. Cumin, Camels, and Caravans: A Spice Odyssey; University of California Press: Berkeley, CA, USA, 2014; Volume 45. [Google Scholar]
- Mazur, S.; Nawrocki, J. Fungal diseases threat on caraway plantations in the south region of Poland. Acta Fytotech. Zootech. 2004, 7, 201–203. [Google Scholar]
- Khalil, A.M.; Ahmed, A.F.; Mahmoud, E.E.; Abdelaziz, A.M. Influence of organic farming system on microbial biomass and fungal communities of agricultural soil. Afr. J. Mycol. Biotechnol. 2015, 20, 23–40. [Google Scholar]
- Alamri, M.; Alghamdi, H.; Althawadi, S.; Mutabaggani, M.; Dababo, M.A.; Alajlan, F.; Alzayer, M.; Doumith, M.; Alghoribi, M.; Almaghrabi, R.S. Invasive fungal infection of the brain caused by Neoscytalidium dimidiatum in a post-renal transplant patient: A case report. Med. Mycol. Case Rep. 2021, 34, 27–31. [Google Scholar] [CrossRef] [PubMed]
- Elshafie, A.E.; Ba-Omar, T. First report of Albizia lebbeck dieback caused by Scytalidium dimidiatum in Oman. Mycopathologia 2002, 154, 37–40. [Google Scholar] [CrossRef] [PubMed]
- Alizadeh, A.; Heidarian, A.; Farrokhi-Nejad, R. Citrus branch wilt, decline and death caused by Nattrassia mangiferae and its other hosts in Khuzestan province. Iran. J. Plant Pathol. 2000, 36, Pe77–Pe97. [Google Scholar]
- Al Raish, S.M.; Saeed, E.E.; Sham, A.; Alblooshi, K.; El-Tarabily, K.A.; AbuQamar, S.F. Molecular characterization and disease control of stem canker on royal poinciana (Delonix regia) caused by Neoscytalidium dimidiatum in the United Arab Emirates. Int. J. Mol. Sci. 2020, 21, 1033. [Google Scholar] [CrossRef]
- Abdelaziz, A.M.; Hashem, A.H.; El-Sayyad, G.S.; El-Wakil, D.A.; Selim, S.; Alkhalifah, D.H.M.; Attia, M.S. Biocontrol of soil borne diseases by plant growth promoting rhizobacteria. Trop. Plant Pathol. 2023, 48, 105–127. [Google Scholar] [CrossRef]
- Abdelaziz, A.M.; Kalaba, M.H.; Hashem, A.H.; Sharaf, M.H.; Attia, M.S. Biostimulation of tomato growth and biocontrol of Fusarium wilt disease using certain endophytic fungi. Bot. Stud. 2022, 63, 34. [Google Scholar] [CrossRef]
- Attia, M.S.; Hashem, A.H.; Badawy, A.A.; Abdelaziz, A.M. Biocontrol of early blight disease of eggplant using endophytic Aspergillus terreus: Improving plant immunological, physiological and antifungal activities. Bot. Stud. 2022, 63, 26. [Google Scholar] [CrossRef]
- Abdelaziz, A.M.; Elshaer, M.A.; Abd-Elraheem, M.A.; Ali, O.M.O.M.; Haggag, M.I.; El-Sayyad, G.S.; Attia, M.S. Ziziphus spina-christi extract-stabilized novel silver nanoparticle synthesis for combating Fusarium oxysporum-causing pepper wilt disease: In vitro and in vivo studies. Arch. Microbiol. 2023, 205, 69. [Google Scholar] [CrossRef] [PubMed]
- Farrag, A.; Attia, M.S.; Younis, A.; Abd Elaziz, A. Potential impacts of elicitors to improve tomato plant disease resistance. Al Azhar. Bull. Sci. 2017, 9, 311–321. [Google Scholar]
- Attia, M.S.; El-Wakil, D.A.; Hashem, A.H.; Abdelaziz, A.M. Antagonistic Effect of Plant Growth-Promoting Fungi Against Fusarium Wilt Disease in Tomato: In vitro and In vivo Study. Appl. Biochem. Biotechnol. 2022, 194, 5100–5118. [Google Scholar] [CrossRef] [PubMed]
- Abdelaziz, A.M.; El-Wakil, D.A.; Attia, M.S.; Ali, O.M.; AbdElgawad, H.; Hashem, A.H. Inhibition of Aspergillus flavus growth and aflatoxin production in Zea mays L. using endophytic Aspergillus fumigatus. J. Fungi 2022, 8, 482. [Google Scholar] [CrossRef]
- Attia, M.S.; Younis, A.M.; Ahmed, A.F.; Elaziz, A. Comprehensive management for wilt disease caused by Fusarium oxysporum in tomato plant. Int. J. Innov. Sci. Eng. Technol. 2016, 4, 2348–7968. [Google Scholar]
- Abdelaziz, A.M.; Salem, S.S.; Khalil, A.M.A.; El-Wakil, D.A.; Fouda, H.M.; Hashem, A.H. Potential of biosynthesized zinc oxide nanoparticles to control Fusarium wilt disease in eggplant (Solanum melongena) and promote plant growth. BioMetals 2022, 35, 601–616. [Google Scholar] [CrossRef]
- Hashem, A.H.; Abdelaziz, A.M.; Attia, M.S.; Salem, S.S. Selenium and nano-selenium-mediated biotic stress tolerance in plants. In Selenium and Nano-Selenium in Environmental Stress Management and Crop Quality Improvement; Springer: Berlin/Heidelberg, Germany, 2022; pp. 209–226. [Google Scholar]
- Das, P.; Karankar, V.S. New avenues of controlling microbial infections through anti-microbial and anti-biofilm potentials of green mono-and multi-metallic nanoparticles: A review. J. Microbiol. Methods 2019, 167, 105766. [Google Scholar] [CrossRef] [PubMed]
- Elbasuney, S.; El-Sayyad, G.S.; Attia, M.S.; Abdelaziz, A.M. Ferric oxide colloid: Towards green nano-fertilizer for tomato plant with enhanced vegetative growth and immune response against fusarium wilt disease. J. Inorg. Organomet. Polym. Mater. 2022, 32, 4270–4283. [Google Scholar] [CrossRef]
- Khattab, A.M.; Abo-Taleb, H.A.; Abdelaziz, A.M.; El-Tabakh, M.A.M.; El-Feky, M.M.M.; Abu-Elghait, M. Daphnia magna and Gammarus pulex, novel promising agents for biomedical and agricultural applications. Sci. Rep. 2022, 12, 13690. [Google Scholar] [CrossRef] [PubMed]
- Raveau, R.; Fontaine, J.; Sahraoui, A.L.-H. Essential oils as potential alternative biocontrol products against plant pathogens and weeds: A review. Foods 2020, 9, 365. [Google Scholar] [CrossRef] [PubMed]
- Aguilar-Veloz, L.M.; Calderón-Santoyo, M.; González, Y.V.; Ragazzo-Sánchez, J.A. Application of essential oils and polyphenols as natural antimicrobial agents in postharvest treatments: Advances and challenges. Food Sci. Nutr. 2020, 8, 2555–2568. [Google Scholar] [CrossRef]
- Veloz-García, R.; Marín-Martínez, R.; Veloz-Rodríguez, R.; Rodríguez-Guerra, R.; Torres-Pacheco, I.; González-Chavira, M.M.; Anaya-López, J.L.; Guevara-Olvera, L.; Feregrino-Pérez, A.A.; Loarca-Piña, G.; et al. Antimicrobial activities of cascalote (Caesalpinia cacalaco) phenolics-containing extract against fungus Colletotrichum lindemuthianum. Ind. Crops Prod. 2010, 31, 134–138. [Google Scholar] [CrossRef]
- Yang, R.; Miao, J.; Chen, X.; Chen, C.; Simal-Gandara, J.; Chen, J.; Wan, C. Essential oils nano-emulsion confers resistance against Penicillium digitatum in ‘Newhall’ navel orange by promoting phenylpropanoid metabolism. Ind. Crops Prod. 2022, 187, 115297. [Google Scholar] [CrossRef]
- Giunti, G.; Palermo, D.; Laudani, F.; Algeri, G.M.; Campolo, O.; Palmeri, V. Repellence and acute toxicity of a nano-emulsion of sweet orange essential oil toward two major stored grain insect pests. Ind. Crops Prod. 2019, 142, 111869. [Google Scholar] [CrossRef]
- Purdy, L.H. Sclerotinia sclerotiorum: History, diseases and symptomatology, host range, geographic distribution, and impact. Phytopathology 1979, 69, 875–880. [Google Scholar] [CrossRef]
- Crous, P.W.; Slippers, B.; Wingfield, M.J.; Rheeder, J.; Marasas, W.F.O.; Philips, A.J.L.; Alves, A.; Burgess, T.; Barber, P.; Groenewald, J.Z. Phylogenetic lineages in the Botryosphaeriaceae. Stud. Mycol. 2006, 55, 235–253. [Google Scholar] [CrossRef]
- Phillips, A.J.L.; Alves, A.; Abdollahzadeh, J.; Slippers, B.; Wingfield, M.J.; Groenewald, J.Z.; Crous, P.W. The Botryosphaeriaceae: Genera and species known from culture. Stud. Mycol. 2013, 76, 51–167. [Google Scholar] [CrossRef]
- Huang, S.K.; Tangthirasunun, N.; Phillips, A.J.; Dai, D.Q.; Wanasinghe, D.N.; Wen, T.C.; Bahkali, A.H.; Hyde, K.D.; Kang, J.C. Morphology and Phylogeny of Neoscytalidium orchidacearum sp. nov. (Botryosphaeriaceae). Mycobiology 2016, 44, 79–84. [Google Scholar] [CrossRef]
- Liu, D.; Pearce, L.; Lilley, G.; Coloe, S.; Baird, R.; Pedersen, J. PCR identification of dermatophyte fungi Trichophyton rubrum, T. soudanense and T. gourvilii. J. Med. Microbiol. 2002, 51, 117–122. [Google Scholar] [CrossRef]
- Kumar, S.; Stecher, G.; Li, M.; Knyaz, C.; Tamura, K. MEGA X: Molecular evolutionary genetics analysis across computing platforms. Mol. Biol. Evol. 2018, 35, 1547. [Google Scholar] [CrossRef]
- Al-Shahrani, M.H.; Mahfoud, M.; Anvarbatcha, R.; Athar, T.; Al Asmari, A. Evaluation of antifungal activity and cytotoxicity of Thymus vulgaris essential oil. Pharmacogn. Commun. 2017, 7, 34–40. [Google Scholar] [CrossRef]
- Ghotbi, R.S.; Khatibzadeh, M.; Kordbacheh, S. Preparation of neem seed oil nanoemulsion. In Proceedings of the 5th International Conference on Nanotechnology: Fundamentals and Applications, Prague, Czech Republic, 11–13 August 2014. [Google Scholar]
- Saloko, S.; Darmadji, P.; Setiaji, B.; Pranoto, Y.; Anal, A.K. Encapsulation of coconut shell liquid smoke in chitosan-maltodextrin based nanoparticles. Int. Food Res. J. 2013, 20, 1269. [Google Scholar]
- Al-Bedak, O.A.; Mohamed, R.A.; Seddek, N.H. First detection of Neoscytalidium dimidiatum associated with canker disease in Egyptian Ficus trees. For. Pathol. 2018, 48, e12411. [Google Scholar] [CrossRef]
- Bates, L.S.; Waldren, R.P.; Teare, I.D. Rapid determination of free proline for water-stress studies. Plant Soil 1973, 39, 205–207. [Google Scholar] [CrossRef]
- Dai, G.H.; Andary, C.; Cosson-Mondolot, L.; Boubals, D. Polyphenols and resistance of grapevines to downy mildew. In International Symposium on Natural Phenols in Plant Resistance 381; ISHS: Coimbatore, India, 1993. [Google Scholar]
- Hu, Z.; Richter, H.; Sparovek, G.; Schnug, E. Physiological and biochemical effects of rare earth elements on plants and their agricultural significance: A review. J. Plant Nutr. 2004, 27, 183–220. [Google Scholar] [CrossRef]
- Mukherjee, S.P.; Choudhuri, M.A. Implications of water stress-induced changes in the levels of endogenous ascorbic acid and hydrogen peroxide in Vigna seedlings. Physiol. Plant. 1983, 58, 166–170. [Google Scholar] [CrossRef]
- Srivastava, S. Peroxidase and poly-phenol oxidase in Brassica juncea plants infected with Macrophomina phaseolina (Tassai) Goid and their implication in disease resistance. J. Phytopathol. 1987, 120, 249–254. [Google Scholar] [CrossRef]
- Matta, A. Accumulation of phenols in tomato plants infected by different forms of Fusarium oxysporum. Phytopathology 1969, 59, 512–513. [Google Scholar]
- Snedecor, G.W.; Cochran, W.G. Statistical Methods, 2nd ed.; Iowa State University Press: Ames, IA, USA, 1982; Volume 507. [Google Scholar]
- Mohd, M.H.; Salleh, B.; Zakaria, L. Identification and molecular characterizations of Neoscytalidium dimidiatum causing stem canker of red-fleshed dragon fruit (Hylocereus polyrhizus) in Malaysia. J. Phytopathol. 2013, 161, 841–849. [Google Scholar] [CrossRef]
- Derviş, S.; Özer, G.; Türkölmez, Ş. First report of Neoscytalidium dimidiatum causing tuber rot of potato in Turkey. J. Plant Pathol. 2020, 102, 1295–1296. [Google Scholar] [CrossRef]
- Ghosh, V.; Mukherjee, A.; Chandrasekaran, N. Eugenol-loaded antimicrobial nanoemulsion preserves fruit juice against, microbial spoilage. Colloids Surf. B Biointerfaces 2014, 114, 392–397. [Google Scholar] [CrossRef] [PubMed]
- de Oliveira, A.M.; Jäger, E.; Jäger, A.; Stepánek, P.; Giacomelli, F.C. Physicochemical aspects behind the size of biodegradable polymeric nanoparticles: A step forward. Colloids Surf. A Physicochem. Eng. Asp. 2013, 436, 1092–1102. [Google Scholar] [CrossRef]
- Sajjadi, S.; Zerfa, M.; Brooks, B.W. Dynamic behaviour of drops in oil/water/oil dispersions. Chem. Eng. Sci. 2002, 57, 663–675. [Google Scholar] [CrossRef]
- Sampathi, S.; Mankala, S.K.; Wankar, J.; Dodoala, S. Nanoemulsion Based Hydrogels of Itraconazole for Transdermal Drug Delivery; NISCAIR-CSIR: New Delhi, India, 2015. [Google Scholar]
- Hammad, E.A.; Hasanin, M.M.H. Antagonistic Effect of Nanoemulsions of Some Essential Oils against Fusarium oxysporum and Root-Knot Nematode Meloidogyne javanica on Coleus Plants. Pak. J. Nematol. 2022, 40, 35–48. [Google Scholar] [CrossRef]
- Morcia, C.; Malnati, M.; Terzi, V. In vitro antifungal activity of terpinen-4-ol, eugenol, carvone, 1, 8-cineole (eucalyptol) and thymol against mycotoxigenic plant pathogens. Food Addit. Contam. Part A 2012, 29, 415–422. [Google Scholar]
- Matan, N.; Nisoa, M.; Matan, N.; Aewsiri, T. Effect of cold atmospheric plasma on antifungal activities of clove oil and eugenol against molds on areca palm (Areca catechu) leaf sheath. Int. Biodeterior. Biodegrad. 2014, 86, 196–201. [Google Scholar] [CrossRef]
- e Oliveira Pereira, F.; Mendes, J.M.; de Oliveira Lima, E. Investigation on mechanism of antifungal activity of eugenol against Trichophyton rubrum. Med. Mycol. 2013, 51, 507–513. [Google Scholar] [CrossRef]
- Gill, A.; Holley, R. Inhibition of membrane bound ATPases of Escherichia coli and Listeria monocytogenes by plant oil aromatics. Int. J. Food Microbiol. 2006, 111, 170–174. [Google Scholar] [CrossRef]
- Braga, P.; Sasso, M.D.; Culici, M.; Alfieri, M. Eugenol and thymol, alone or in combination, induce morphological alterations in the envelope of Candida albicans. Fitoterapia 2007, 78, 396–400. [Google Scholar] [CrossRef]
- Amiri, A.; Dugas, R.; Pichot, A.L.; Bompeix, G. In vitro and in vitro activity of eugenol oil (Eugenia caryophylata) against four important postharvest apple pathogens. Int. J. Food Microbiol. 2008, 126, 13–19. [Google Scholar] [CrossRef]
- Hassanin, M. Pathological Studies on Root Rot and Wilt of Black Cumin (Nigella sativa) and Their Management in Egypt. Ph.D. Thesis, Faculty of Agriculture, Al-Azhar University, Cairo, Egypt, 2013; 137p. [Google Scholar]
- Shahbazi, Y. Antioxidant, antibacterial, and antifungal properties of nanoemulsion of clove essential oil. Nanomed. Res. J. 2019, 4, 204–208. [Google Scholar]
- Šernaitė, L.; Rasiukevičiūtė, N.; Valiuškaitė, A. The Extracts of cinnamon and clove as potential biofungicides against strawberry grey mould. Plants 2020, 9, 613. [Google Scholar] [CrossRef] [PubMed]
- Mahdi, A.A.; Al-Maqtari, Q.A.; Mohammed, J.K.; Al-Ansi, W.; Cui, H.; Lin, L. Enhancement of antioxidant activity, antifungal activity, and oxidation stability of Citrus reticulata essential oil nanocapsules by clove and cinnamon essential oils. Food Biosci. 2021, 43, 101226. [Google Scholar] [CrossRef]
- Bagherabadi, S.; Zafari, D.; Maharachchikumbura, S.S. Neoscytalidium dimidiatum as One of the Fungal Agents Associated with Walnut Decline in Iran. J. Nuts 2022, 13, 31–39. [Google Scholar]
- Güney, I.G.; Özer, G.; Türkölmez, Ş.; Derviş, S. Canker and leaf scorch on olive (Olea europaea L.) caused by Neoscytalidium dimidiatum in Turkey. Crop Prot. 2022, 157, 105985. [Google Scholar] [CrossRef]
- Tuan, L.N.A.; Du, B.D.; Ha, L.D.T.; Dzung, L.T.K.; Van Phu, D.; Hien, N.Q. Induction of chitinase and brown spot disease resistance by oligochitosan and nanosilica–oligochitosan in dragon fruit plants. Agric. Res. 2019, 8, 184–190. [Google Scholar] [CrossRef]
- Hou, T.; Sana, S.S.; Li, H.; Xing, Y.; Nanda, A.; Netala, V.R.; Zhang, Z. Essential oils and its antibacterial, antifungal and anti-oxidant activity applications: A review. Food Biosci. 2022, 47, 101716. [Google Scholar] [CrossRef]
- Milind, P.; Deepa, K. Clove: A champion spice. Int. J. Res. Ayurveda Pharm. 2011, 2, 47–54. [Google Scholar]
- Ertas, O.N.; Guler, T.; Çiftçi, M.; DalkIlIç, B.; Simsek, U.G. The effect of an essential oil mix derived from oregano, clove and anise on broiler performance. Int. J. Poult. Sci. 2005, 4, 879–884. [Google Scholar]
- Sattary, M.; Amini, J.; Hallaj, R. Antifungal activity of the lemongrass and clove oil encapsulated in mesoporous silica nanoparticles against wheat’s take-all disease. Pestic. Biochem. Physiol. 2020, 170, 104696. [Google Scholar] [CrossRef]
- Sharma, A.; Shahzad, B.; Kumar, V.; Kohli, S.K.; Sidhu, G.P.S.; Bali, A.S.; Handa, N.; Kapoor, D.; Bhardwaj, R.; Zheng, B. Phytohormones regulate accumulation of osmolytes under abiotic stress. Biomolecules 2019, 9, 285. [Google Scholar] [CrossRef] [PubMed]
- Rejeb, K.B.; Abdelly, C.; Savouré, A. How reactive oxygen species and proline face stress together. Plant Physiol. Biochem. 2014, 80, 278–284. [Google Scholar] [CrossRef] [PubMed]
- Lucas, G.C.; Alves, E.; Pereira, R.B.; Zacaroni, A.; Perina, F.; de Souza, R.M. Indian clove essential oil in the control of tomato bacterial spot. J. Plant Pathol. 2012, 94, 45–51. [Google Scholar]
- Kumar, P.; Lokesh, V.; Doddaraju, P.; Kumari, A.; Singh, P.; Meti, B.S.; Sharma, J.; Gupta, K.J.; Manjunatha, G. Greenhouse and field experiments revealed that clove oil can effectively reduce bacterial blight and increase yield in pomegranate. Food Energy Secur. 2021, 10, e305. [Google Scholar] [CrossRef]
- Shafie, R. Antiviral Activity of Clove Oil Nanoemulsion against Potato virus-Y (PVY). Egypt. J. Phytopathol. 2017, 45, 15–31. [Google Scholar] [CrossRef]
- Fayez, K.A.; Al-Sodany, Y.M.; Abouzaid, A. Impact of greenhouse environmental factors and fungicide Trinol (triadimend) treatment on berry leaves infected with powdery mildew (Uncinula necator (Schwein.) Burrill: Role of host antioxidant systems against pathogen infection. Res. J. Pharm. Biol. Chem. Sci. 2016, 7, 3058–3072. [Google Scholar]
- Attia, M.S.; El-Naggar, H.A.; Abdel-Daim, M.M.; El-Sayyad, G.S. The potential impact of Octopus cyanea extracts to improve eggplant resistance against Fusarium-wilt disease: In vivo and in vitro studies. Environ. Sci. Pollut. Res. 2021, 28, 35854–35869. [Google Scholar] [CrossRef]
- Albalawi, M.A.; Abdelaziz, A.M.; Attia, M.S.; Saied, E.; Elganzory, H.H.; Hashem, A.H. Mycosynthesis of Silica Nanoparticles Using Aspergillus niger: Control of Alternaria solani Causing Early Blight Disease, Induction of Innate Immunity and Reducing of Oxidative Stress in Eggplant. Antioxidants 2022, 11, 2323. [Google Scholar] [CrossRef]
- Lattanzio, V.; Lattanzio, V.M.; Cardinali, A. Role of phenolics in the resistance mechanisms of plants against fungal pathogens and insects. Phytochem. Adv. Res. 2006, 661, 23–67. [Google Scholar]
- Aldinary, A.M.; Abdelaziz, A.M.; Farrag, A.A.; Attia, M.S. Biocontrol of tomato Fusarium wilt disease by a new Moringa endophytic Aspergillus isolates. Mater. Today Proc. 2021, in press. [Google Scholar] [CrossRef]
- Brewer, M. Natural antioxidants: Sources, compounds, mechanisms of action, and potential applications. Compr. Rev. Food Sci. Food Saf. 2011, 10, 221–247. [Google Scholar] [CrossRef]
- Moghaddam, M.R.B.; Le Roy, K.; Xiang, L.; Rolland, F.; Ende, W.V.D. Sugar signalling and antioxidant network connections in plant cells. FEBS J. 2010, 277, 2022–2037. [Google Scholar] [CrossRef]
- Sharma, A.; Sharma, N.K.; Srivastava, A.; Kataria, A.; Dubey, S.; Sharma, S.; Kundu, B. Clove and lemongrass oil based non-ionic nanoemulsion for suppressing the growth of plant pathogenic Fusarium oxysporum f. sp. lycopersici. Ind. Crops Prod. 2018, 123, 353–362. [Google Scholar] [CrossRef]
- Jain, A.; Singh, A.; Singh, S.; Singh, H.B. Microbial consortium-induced changes in oxidative stress markers in pea plants challenged with Sclerotinia sclerotiorum. J. Plant Growth Regul. 2013, 32, 388–398. [Google Scholar] [CrossRef]
- Hosseinifard, M.; Stefaniak, S.; Javid, M.G.; Soltani, E.; Wojtyla, Ł.; Garnczarska, M. Contribution of exogenous proline to abiotic stresses tolerance in plants: A review. Int. J. Mol. Sci. 2022, 23, 5186. [Google Scholar] [CrossRef]
- Dallagnol, L.J.; Rodrigues, F.A.; Martins, S.C.V.; Cavatte, P.C.; DaMatta, F.M. Alterations on rice leaf physiology during infection by Bipolaris oryzae. Australas. Plant Pathol. 2011, 40, 360–365. [Google Scholar] [CrossRef]
- Badawy, A.; Alotaibi, M.; Abdelaziz, A.; Osman, M.; Khalil, A.; Saleh, A.; Mohammed, A.; Hashem, A. Enhancement of Seawater Stress Tolerance in Barley by the Endophytic Fungus Aspergillus ochraceus. Metabolites 2021, 11, 428. [Google Scholar] [CrossRef]
- Dwivedy, A.K.; Kumar, M.; Upadhyay, N.; Prakash, B.; Dubey, N. Plant essential oils against food borne fungi and mycotoxins. Curr. Opin. Food Sci. 2016, 11, 16–21. [Google Scholar] [CrossRef]
- Basavegowda, N.; Baek, K.-H. Synergistic antioxidant and antibacterial advantages of essential oils for food packaging applications. Biomolecules 2021, 11, 1267. [Google Scholar] [CrossRef]
- Jiang, S.; Han, S.; He, D.; Cao, G.; Fang, K.; Xiao, X.; Yi, J.; Wan, X. The accumulation of phenolic compounds and increased activities of related enzymes contribute to early defense against walnut blight. Physiol. Mol. Plant Pathol. 2019, 108, 101433. [Google Scholar] [CrossRef]
- Alici, E.H.; Arabaci, G. Determination of SOD, POD, PPO and cat enzyme activities in Rumex obtusifolius L. Annu. Res. Rev. Biol. 2016, 11, 1–7. [Google Scholar] [CrossRef]
- Gill, S.S.; Tuteja, N. Reactive oxygen species and antioxidant machinery in abiotic stress tolerance in crop plants. Plant Physiol. Biochem. 2010, 48, 909–930. [Google Scholar] [CrossRef] [PubMed]
Disclaimer/Publisher’s Note: The statements, opinions and data contained in all publications are solely those of the individual author(s) and contributor(s) and not of MDPI and/or the editor(s). MDPI and/or the editor(s) disclaim responsibility for any injury to people or property resulting from any ideas, methods, instructions or products referred to in the content. |
© 2023 by the authors. Licensee MDPI, Basel, Switzerland. This article is an open access article distributed under the terms and conditions of the Creative Commons Attribution (CC BY) license (https://creativecommons.org/licenses/by/4.0/).